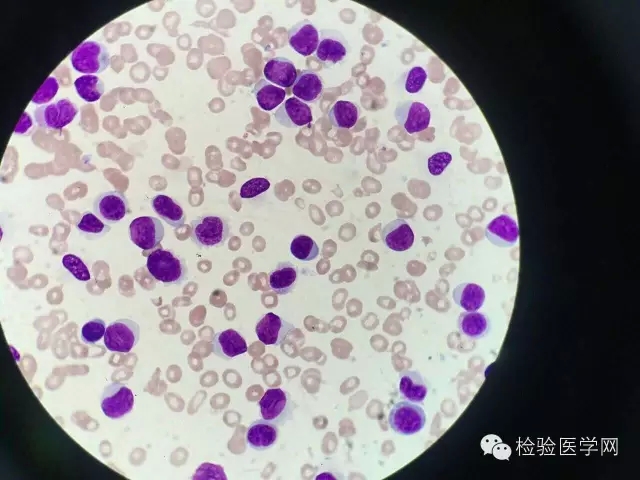
\
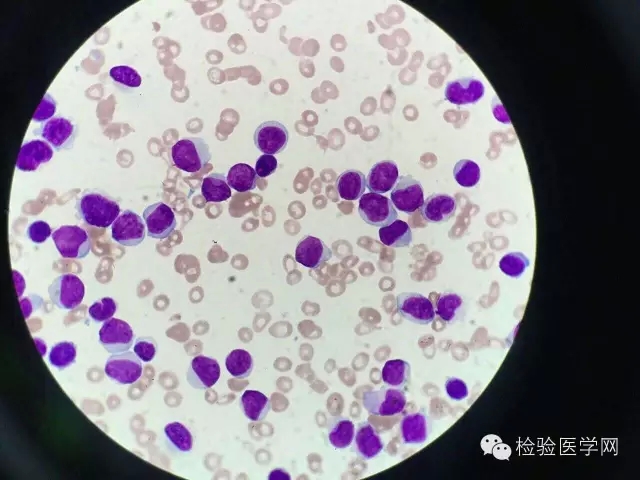
\
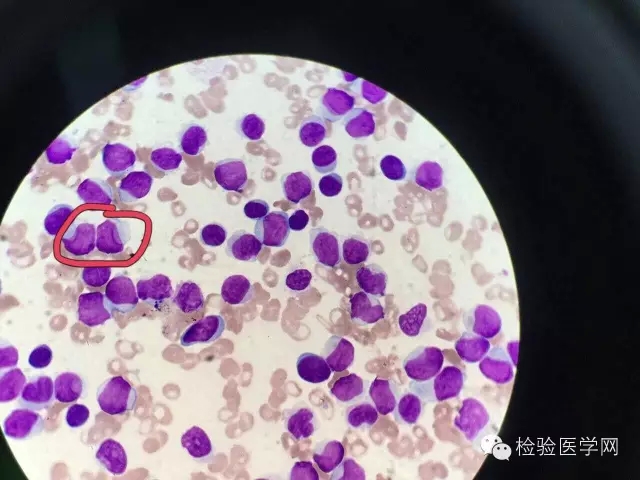
\

杯口细胞是个啥东东?
3月22日,鄂尔多斯中心医院李洪文在全国血液细胞形态学微信群分享的病例:
外周血涂片,倾向? 男性,70岁,白细胞增高。
协和医院蒋显勇、成都中医药大学冷平两位老师指出:存在杯口细胞
协和医院蒋显勇分享的文献
以下是文献翻译:
急性髓系白血病“杯状”原始细胞伴随FLT3和NPM1基因突变
一名61岁的老年患者出现左侧颈部疼痛和肿胀,头晕,盗汗,体重显著减轻。实验室检查显示全血细胞减少,血红蛋白为8.6g/dL,白细胞计数显示白细胞600个每/ul,血小板1500个每ul。骨髓穿刺检查显示原始细胞占90% (图A)和细胞核伴随一种特有的 “杯状”形态(图B)。分子生物学检测显示同时存在NPM1和FLT3的突变。细胞遗传学的检查显示无任何异常。病人使用阿糖胞苷和去甲基柔红霉素诱导化疗,显示有良好的治疗反应。
急性髓系白血病是一个复杂的诊断,需要多种方法进行联合,包括形态学、免疫表型和遗传学。杯状核形态和NPM1与 FLT3的同时突变有密切联系,这种形态也可以是单独的NPM1突变,也可以不伴FLT3突变。此外,这种髓系白血病通常显示为正常核型,高D二聚体,不表达CD34和HLA-DR。因为这些独特的特征,识别这种形态后建议后续做FLT3和NPM1基因突变的检测。
参与讨论专家:
第三军医大学西南医院-杨再林
保定市第一医院-王哲
浙江中大附院-王剑超
天津血研所-肖继刚
协和医院-蒋显勇
成都中医药大学-冷平
......
杯状核细胞:是指原始细胞有杯口样的核,(即有明显的核内陷程度大于核的25%),细胞比例常大于10%,又称“杯口细胞”或“鱼嘴样细胞”。常与伴有NPM1基因突变的急性髓细胞白血病有较强的相关性,但可以是AML的任何类型。国外报道常见于急性单核细胞白血病或者急性粒单核细胞白血病,国内一些学者则认为M1、M2、M5均比较常见。
杯口细胞对于鉴别急性白血病是否为髓系与淋系有很重要的意义,而在粒细胞与单核细胞的区分上并不可靠。这种形态的AML常伴有NPM1基因的突变,大约40%同时还伴有FLT3-ITD基因的突变。就NPM1与FLT3-ITD突变而言,根据2014版NCCN指南,AML遗传学改变与临床预后危险程度分级为:单纯NPM1+ FLT3-ITD-的AML为低危,预后较好,NPM1+ FLT3-ITD+为中危,预后次之,NPM1- FLT3-ITD+的AML为高危,预后最差。
临床表现一般为:常无MDS、MPN病史,一般表现为贫血、血小板减少,白细胞计数较一般的AML高,部分可有髓外浸润,一般累及牙龈、淋巴结、皮肤等。典型病例常见于正常核型的老年人,也可见于年龄较小的AML。
伴NPM1突变的AML原始细胞常高表达33和123,表达髓系标志CD13、MPO、CD117、CD64,常不表达CD34、HLA-DR,少数例外。染色体一般为正常核型。
(本网站所有内容,凡注明来源为“检验医学网”,版权均归检验医学网(www.labmed.cn)所有,未经许可严禁转载,否则将追究法律责任。本网注明来源为其他媒体的内容为转载,转载仅作观点分享,版权归原作者所有,如有侵犯版权,请及时联系我们。)